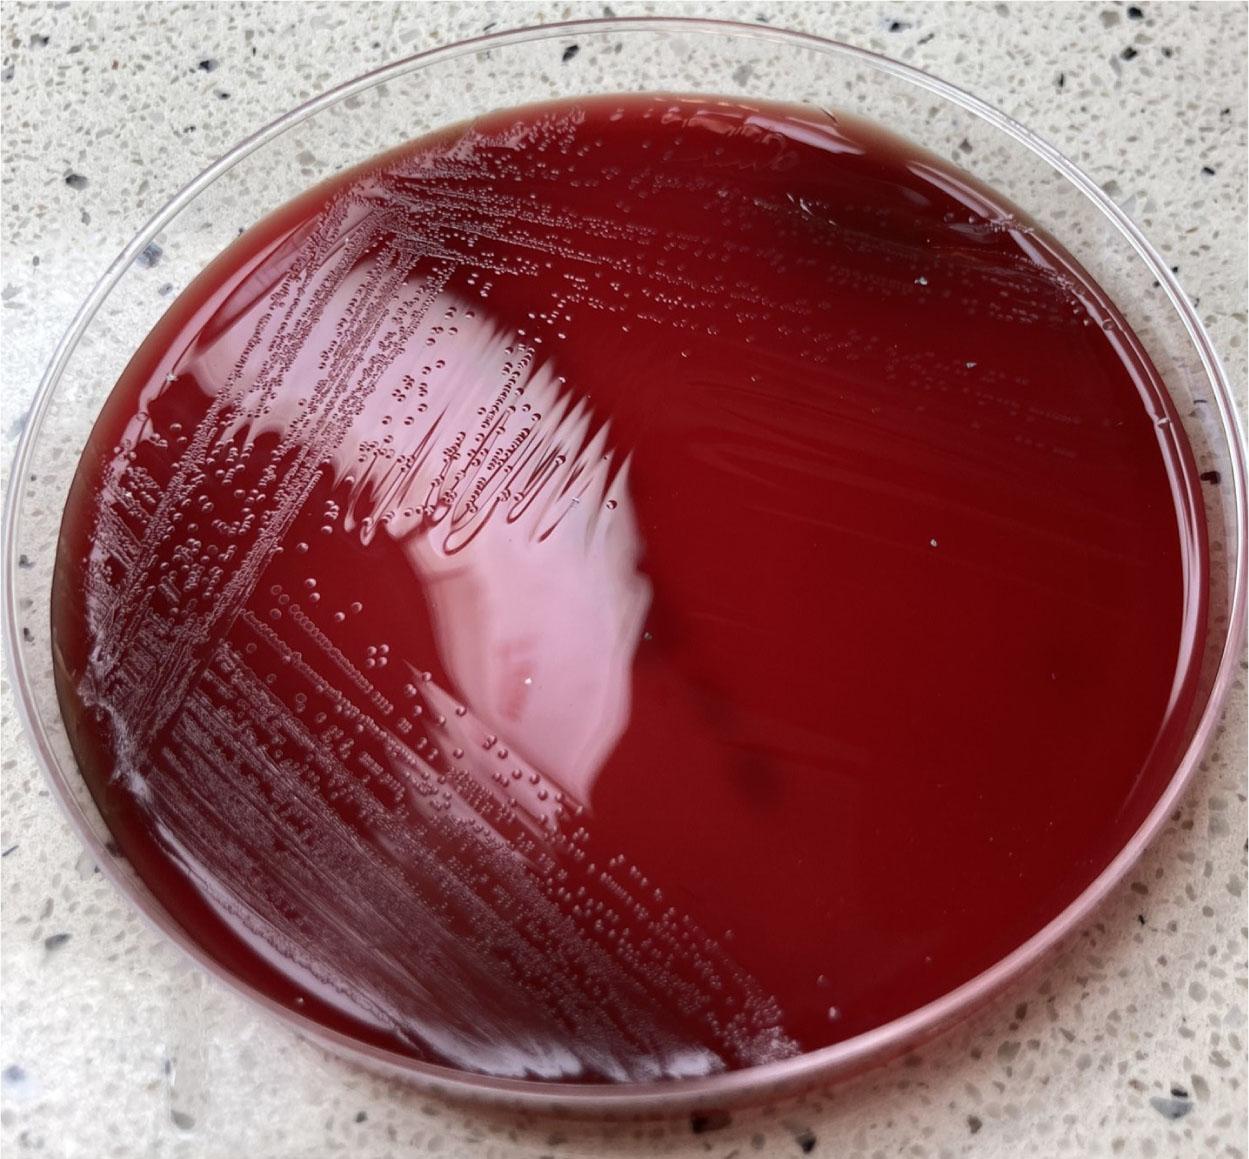
The growth of Psychrobacter sp. described in the report on Columbia Agar with 5% sheep blood.

Fig. 1.

Fig. 2.

Fig. 3.
Fig. 4.

Susceptibility profile of Psychrobacter sanguinis obtained from blood culture during hospitalization_
| Antibiotic | Susceptibility |
|---|---|
| Amoxicillin/clavulanic acid | S |
| Piperacillin/tazobactam | S |
| Cefotaxime | S |
| Cefepime | S |
| Imipenem | S |
| Meropenem | S |
| Ciprofloxacin | R |
Susceptibility profile of Streptococcus pyogenes as on the wound swab culture during hospitalization_
| Antibiotic | Susceptibility |
|---|---|
| Benzylpenicillin | S |
| Erythromycin | S |
| Clindamycin | S |
| Linezolid | S |
| Vancomycin | S |